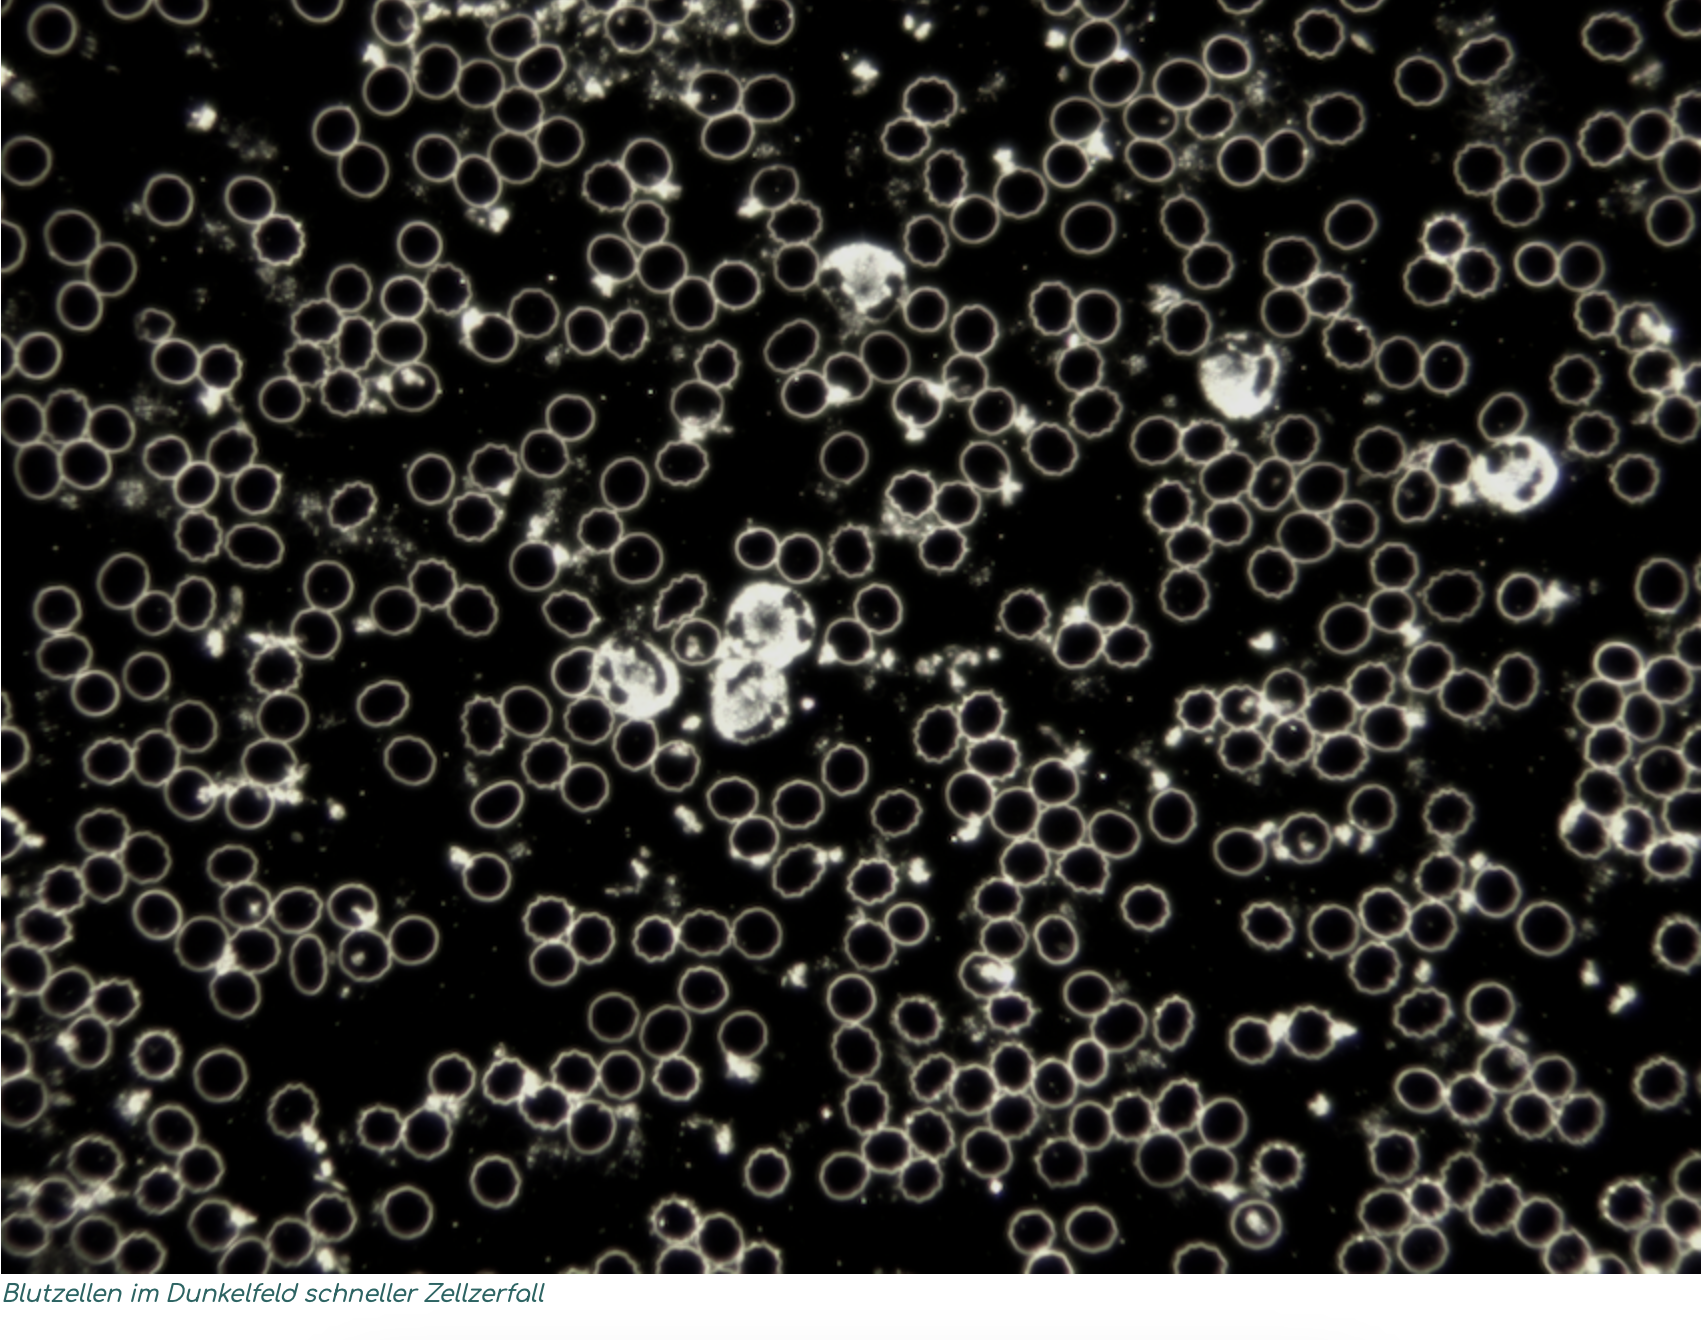

Die Heilmethoden in unserer Praxis basieren auf diagnostischen und therapeutischen Verfahren, die in Verbindung von Tradition und moderner Wissenschaft entwickelt wurden und somit ganzheitlich und bedarfsgerecht eingesetzt werden können. Durch die enge Zusammenarbeit mit Fachärzten, Labors und Kliniken können auch schwere Erkrankungen verantwortungsvoll naturheilkundlich behandelt werden.
Jeder Therapie geht eine ausführliche Erstuntersuchung voraus, bei der Ihre Konstitution und Ihr aktueller Gesundheitszustand diagnostiziert werden. Anschließend erhalten Sie einen schriftlichen Gesundheitsplan zur Umsetzung der gemeinsam ausgewählten Therapiemaßnahmen.
Vorträge
25.05.2024 – Herz-Kreislauf-Erkrankungen vorbeugen
22.06.2024 – Gesundes Alter
13.07.2024 – Nie wieder Einsamkeit
Rufen Sie uns an
0171 44 33 8 55
Unsere Adressen
Unterer Lüßbach 7 Tal 39
82335 Berg 80331 München
Hausbesuch ist möglich
Phytotherapie & Co
Immer mehr Menschen wenden sich komplementären und alternativen Heilmethoden (CAM) zu, sei es zur Linderung von Beschwerden, zur Förderung des Wohlbefindens oder als Ergänzung zu einer schulmedizinischen Behandlung.
Es ist sinnvoll, diese Methoden nicht als Alternative zur Schulmedizin zu betrachten, sondern als ergänzende Optionen, die zusammen mit schulmedizinischen Interventionen eingesetzt werden können.
Infusionen & Injektionen
Einer der Hauptvorteile einer solchen Therapie ist die sofortige Verfügbarkeit und Absorption der Nährstoffe im Vergleich zur oralen Einnahme von Tabletten und Kapseln. Durch die direkte Verabreichung in die Blutbahn werden die Nährstoffe sofort im Körper verteilt, verstoffwechselt und stehen den Körperzellen direkt zur Verfügung
Dunkelfeldmikroskopie
Die Dunkelfeldmikroskopie ist eine spezielle Form der Diagnostik, bei der dem Patienten ein kleiner Tropfen Kapillarblut aus dem Finger entnommen wird. Das Blut wird über mehrere Stunden unter einem Dunkelfeldmikroskop untersucht, das alles, was sich im Blut befindet, auch optisch sichtbar macht. So blicken wir in den Mikrokosmos des Blutes. So können sonst unsichtbare Phänomene beobachtet werden, die Rückschlüsse auf bestehende Erkrankungen, aber auch auf sich erst in Zukunft manifestierende Krankheitstendenzen zulassen. Sie beginnen bereits dort, wo die Laborparameter noch “normal” sind. Im Anschluss an die Dunkelfeldmikroskopie erfolgt die weitere Diagnostik und Therapie.

Ayurveda Medizin
In der ayurvedischen Medizin wird nicht die Krankheit behandelt, sondern der ganze Mensch. In einer liebevollen und achtsamen Atmosphäre erhalten Sie ein umfassendes Behandlungsprogramm mit konstitutionsgerechten Ölmassagen, sanften Reinigungsmethoden und individuellen Ernährungsempfehlungen.




